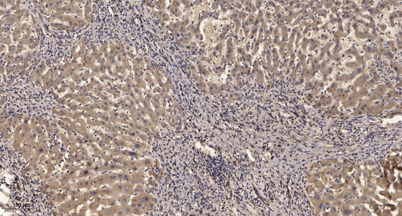

$148.00/50µL $248.00/100µL
| 50 µL | $148.00 |
| 100 µL | $248.00 |
| Product name: | LARG rabbit pAb |
| Reactivity: | Human;Mouse;Rat |
| Alternative Names: | ARHGEF12; KIAA0382; LARG; Rho guanine nucleotide exchange factor 12; Leukemia-associated RhoGEF |
| Source: | Rabbit |
| Dilutions: | WB 1:500-2000;IHC-p 1:50-300 |
| Immunogen: | The antiserum was produced against synthesized peptide derived from human ARHGEF12. AA range:449-498 |
| Storage: | -20°C/1 year |
| Clonality: | Polyclonal |
| Isotype: | IgG |
| Concentration: | 1 mg/ml |
| Observed Band: | 173kD |
| GeneID: | 23365 |
| Human Swiss-Prot No: | Q9NZN5 |
| Cellular localization: | Cytoplasm . Membrane . Translocated to the membrane upon stimulation. . |
| Background: | Rho GTPases play a fundamental role in numerous cellular processes that are initiated by extracellular stimuli working through G protein-coupled receptors. The encoded protein may form a complex with G proteins and stimulate Rho-dependent signals. This protein has been observed to form a myeloid/lymphoid fusion partner in acute myeloid leukemia. Three transcript variants encoding different isoforms have been found for this gene. [provided by RefSeq, Jul 2014], |